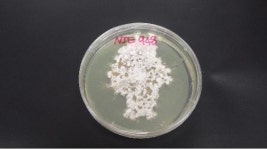
국내 미기록 내생균 2종 발견…침엽수 보존 활용 기대
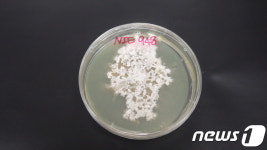
아고산대 침엽수에서 미기록 내생균 2종 발견
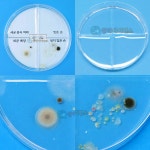
세균증식배양실험 내손의세균관찰하기 바이러스학습교구 4인세트 : 지주스몰

내배양 총131명이 열람하였으며, 0개의 리뷰가 있습니다.
- 시설명
- 내배양
- 시도명
- 경상북도
- 시군구명
- 영천시
- 소재지지번주소
- 경상북도 영천시 청통면 송천리 670
- 총저수량
- 0
- 유효저수량
- 0
- 수혜면적
- 6
- 준공연도
- 1,945
- 관리기관명
- 경상북도 영천시청
- 관리기관전화번호
- 054-330-6747
- 데이터기준일자
- 2024-11-21
- 제공기관코드
- 5,100,000
- 제공기관명
- 경상북도 영천시
주변 목록 (8)
주변 하천 (12)
청통천
경상북도 영천시 신원리
'내배양'에서 2.31km
바로가기
삼부천
경상북도 영천시 가상리
'내배양'에서 8.13km
바로가기
부기천
경상북도 영천시 용덕리
'내배양'에서 9.85km
바로가기
신녕천
경상북도 영천시 치산리
'내배양'에서 10.71km
바로가기
북안천
경상북도 영천시 도천리
'내배양'에서 13.5km
바로가기
봉동천
경상북도 영천시 괴연동
'내배양'에서 14.01km
바로가기
고촌천
경상북도 영천시 덕정리
'내배양'에서 14.85km
바로가기
대창천
경상북도 영천시 운천리
'내배양'에서 15.15km
바로가기
의곡천
경상북도 영천시 오류리
'내배양'에서 15.59km
바로가기
금호강
경상북도 영천시 완산동
'내배양'에서 16.05km
바로가기
선원천
경상북도 영천시 삼매리
'내배양'에서 18.32km
바로가기
횡계천
경상북도 영천시 정각리
'내배양'에서 18.53km
바로가기
주변 낚시터 (12)
평사낚시터
경상북도 경산시 진량읍 평사리 42-2
'내배양'에서 12.81km
바로가기
무태낚시터
'내배양'에서 18.76km
바로가기
동화낚시터
대구광역시 북구 동변로 24길 106(동변동)
'내배양'에서 19.36km
바로가기
삼사낚시터
경상북도 영천시 고경면 추곡길 215-12
'내배양'에서 19.58km
바로가기
눈큰실내낚시터
대구광역시 북구 태전로 57 (태전동)
'내배양'에서 24.68km
바로가기
천평낚시터
경상북도 칠곡군 가산면 금화리 36외 25필지
'내배양'에서 25.08km
바로가기
천평지낚시터
경상북도 칠곡군 가산면 금화리 36외 25필지
'내배양'에서 25.08km
바로가기
두메낚시터
경상북도 경산시 남천면 신방길 39
'내배양'에서 25.41km
바로가기
구봉낚시터
경상북도 칠곡군 지천면 낙산로5길 144-55
'내배양'에서 26.99km
바로가기
대평낚시터
대구광역시 달성군 하빈면 하빈로 832
'내배양'에서 31.01km
바로가기
광지낚시터
경상북도 경주시 건천읍 천포방내길 98-9
'내배양'에서 31.14km
바로가기
가곡낚시터
'내배양'에서 31.41km
바로가기
주변 농어촌 체험 휴양 마을 (12)
은해로운휴양마을
경상북도 영천시 청통면 대동로 423
'내배양'에서 0.64km
바로가기
영천포롱마을
경상북도 영천시 금호읍 대동마을길 60
'내배양'에서 7.98km
바로가기
치산돌담모과마을
경상북도 영천시 신녕면 치산안길 70-13
'내배양'에서 11.32km
바로가기
바람이좋은화산마을
대구광역시 군위군 삼국유사면 화산산성길 65
'내배양'에서 13.26km
바로가기
삼국유사화본마을
대구광역시 군위군 산성면 산성가음로 722
'내배양'에서 18.45km
바로가기
가산산성마을
경상북도 칠곡군 가산면 가산로 891
'내배양'에서 19.99km
바로가기
반곡지마을
경상북도 경산시 남산면 반곡길 13
'내배양'에서 22.65km
바로가기
석산약바람산촌생태마을
대구광역시 군위군 삼국유사면 석산길 193
'내배양'에서 23.19km
바로가기
반곡지농촌체험휴양마을
경상북도 경산시 남산면 서원길 271
'내배양'에서 23.64km
바로가기
정각마을
경상북도 영천시 화북면 정각길 16
'내배양'에서 23.83km
바로가기
반곡지 농촌체험 휴양마을
경상북도 경산시 남산면 서원길 348
'내배양'에서 24.13km
바로가기
보현산권역정각마을
경상북도 영천시 화북면 정각길 71-39
'내배양'에서 24.19km
바로가기
주변 농어촌 민박 (12)
미정민박
경상북도 영천시 청통면 치일리 235
'내배양'에서 0.5km
바로가기
도혜원민박
경상북도 영천시 청통면 계포리 353-17
'내배양'에서 1.23km
바로가기
도화지
경상북도 경산시 와촌면 대한리 131-1
'내배양'에서 2.68km
바로가기
복숭아 펜션
경상북도 경산시 와촌면 대한리 131-12
'내배양'에서 2.68km
바로가기
너른
경상북도 경산시 와촌면 소월리 1394-2
'내배양'에서 3.7km
바로가기
성골농원 민박
'내배양'에서 4.22km
바로가기
포니힐링관광민박
경상북도 경산시 와촌면 소월리 1141-1
'내배양'에서 4.22km
바로가기
스테이지 이플
경상북도 경산시 와촌면 음양리 674
'내배양'에서 4.71km
바로가기
까사디풀리아(casa.di.puglia)
'내배양'에서 5.35km
바로가기
휘명힐링민박
경상북도 영천시 신녕면 연정리 1030번지
'내배양'에서 6.49km
바로가기
전원의 낭만
경상북도 영천시 화산면 삼부리 29
'내배양'에서 7.32km
바로가기
담은민박
경상북도 영천시 금호읍 대미리 940-1
'내배양'에서 8.07km
바로가기
주변 캠핑장 야영장 (12)
은해로운 캠핑장
경상북도 영천시 청통면 대동로 423(체험학습관)
'내배양'에서 0.64km
바로가기
스타글램핑
경상북도 영천시 청통면 구정길 53-77
'내배양'에서 2.04km
바로가기
치산관광지 캠핑장
경상북도 영천시 신녕면 치산관광길 263
'내배양'에서 10.83km
바로가기
삼밭골글램핑
경상북도 영천시 삼밭골길 107
'내배양'에서 11.99km
바로가기
오각놀이공원
경상북도 영천시 화남면 용구길 21
'내배양'에서 13.65km
바로가기
글램코티지
'내배양'에서 14.11km
바로가기
동산계곡야영장
경상북도 군위군 부계면 원효길 129-9
'내배양'에서 14.24km
바로가기
영천솔롱고글램핑
경상북도 영천시 금호읍 칠백로 436
'내배양'에서 14.4km
바로가기
군위댐야영장
경상북도 군위군 고로면 화북3길 38-10
'내배양'에서 14.72km
바로가기
키즈팜야영장(금박산관광농원)
'내배양'에서 14.73km
바로가기
아날로그데이
경상북도 군위군 부계면 원효길 1
'내배양'에서 15.28km
바로가기
㈜오리장림관광농원자동차야영장
'내배양'에서 15.73km
바로가기
NAVER 블로그 검색 결과
-
1차 난자 채취는 29개 채취 3일 배양 2개 동결이 전부였던 터라,,, 8개가 채취된 이번에 과연 신선이식을... 헤헤 누워서 수액맞기 남아나지 않는 내 왼팔 혈관 ㅠ 1시간 수액을 맞으면서 소변을 채운 뒤 이식하러...
또히리의 육아 로그캣(20260521)
블로그 검색 결과
-
휴식기간을 가지고 다음 차수에 반착검사나 자궁경이 가능한지 상담받아보려고 해요 끝까지 포기하지 않을테니 꼭 만나자 아기야 지금까지 평촌마리아 2과 시험관 1차 5일배양 동결이식 후기였습니다 :)
망고의 하루하루(20260626)
블로그 검색 결과
-
5배양 포배기 상급이 이식되서 똘똘한 한채를 기다렸다 생긴게 골프공같아서 골린이라고 부르기 시작함 맛난 샌드위치도 먹고 배아관찰경까지 해서 내 골린이 배아가 잘 분열되는거까지 확인했지 이번엔...
Sam’s❤️blog(20260512)
블로그 검색 결과
-
한 잔 하고~ 저녁에는 소고기도 구워먹고~ 엄마 데리러 온 아빠가 사온 내 최애 왕만두도 먹었답니다 눙물이슈 빼고는 큰 이슈 없이 잘 마친 5일배양 동결이식, 1차 시험관 후기 끝 다음 번에는 피검사후기로...
쪄니로그 ღ(20260520)
블로그 검색 결과
-
첫 이식 실패 후, 쉬고싶었는데, 김진영 원장님께서 언제 좋은 배아가 나올지 모른다고, 해보자고 하셔서 어쩌다 진행한 차수인데, 또, 어찌어찌 하다보니, 4일배양 배아 2개를 이식하게 되었다. 그 이후 후기는...
40대 신혼부부 이야기(20260624)
블로그 검색 결과
-
뽀리뽀뽈입니다;) 올해 5월부터 서울역차병원으로 다니기 시작하면서부터의 일들을 간략하게 후기... 6월 난자채취 7월 자궁경수술 8월 시험관 이식(5일배양, pgt 통.배- 중급) => 실패 9월 난자채취 10월 휴식...
뽈's 노트♥(20251212)
블로그 검색 결과
-
난자 채취 포스팅으로 들어오는 분들이 많아 빠르게 이식 후기를 작성해보려고 해요. ✅ 이식 일정 4/7... 잘 모르겠다면 의사쌤과 상담을 하심 좋을 것 같아요 ✅ 이식 배아 저는 5일 배양한 5일차 눈사람 배아...
30대 주니의 육아하우스(20250818)
블로그 검색 결과
-
원장님께서 내 말을 귀담아 들으시고 복수도 안차고 난소과자극도 없으니 몸이 살짝 부담되도 신선이식 가능하다고 3일보다는 5일배양으로 배아 한개이식하기로! 나이가 아직 만 35세전이라 5일배양은 1개만...
Simple, 있는그대로의 BorA(20260316)
블로그 검색 결과
-
나는 35세 미만이지만 반복착상실패 경험이 있기 때문에 5일배양 1개, 6일배양 1개(등급 높은 배아... 7시 40분쯤 되니 내 이름이 호명됐고, 휴대폰과 맞던 수액을 손에 들고 이식실로 들어갔다. (휴대폰 카메라를...
이것저것 블로그(20251229)
블로그 검색 결과
-
5일 배양 배아는 불수능 1등급을 받은 거라고 보면 된대요 ㅋㅋ그만큼 강한 녀석이라고! 역시 내 자식... 인터넷에 다른 분들 후기를 보면 보통 채취한 수의 절반 정도가 수정이 되고 그 절반이 배아까지...
호랑이는 죽어서 가죽을 남기고, 나는..?(20260613)
블로그 검색 결과
일별 방문 통계
월별 방문 통계
카카오맵 바로가기
카카오맵 위치 기준 길안내
리뷰 (0)
등록된 리뷰가 없습니다.
관련 지도 선택 및 번역
첨부파일






![[보고서]허혈성 뇌손상 치료를 위한 줄기세포 대량배양기술, 생체 내 미세환경 조절 및 응용기술 개발](https://search.pstatic.net/sunny/?type=b150&src=https%3A%2F%2Fnrms.kisti.re.kr%2Fbitextimages%2FTRKO201700011922%2FTRKO201700011922_18_image_1.png)